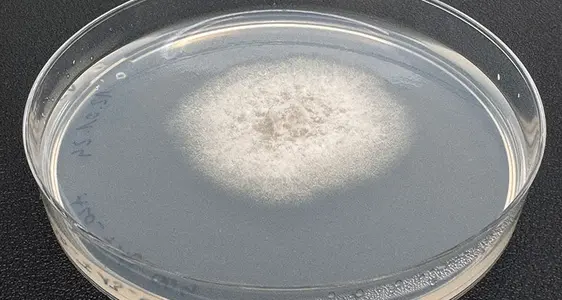
Ein Isolat von Colletotrichum chrysophilum auf Nährmedium

Glomerella Leaf Spot
Die Krankheit Glomerella Leaf Spot (GLS) war bis vor wenigen Jahren auf einzelne subtropische Apfelanbaugebiete in Südamerika, dem Südosten der USA sowie China beschränkt. Im Jahr 2019 wurde die Pilzkrankheit erstmals in der italienischen Region Emilia-Romagna nachgewiesen. Im Jahr 2020 wurden Symptome der Krankheit erstmals auch in Apfelanlagen Südtirols beobachtet. Der Arbeitsgruppe Phytopathologie des Versuchszentrum Laimburg gelang es, den Erreger innerhalb kürzester Zeit nachzuweisen und zu identifizieren (Oettl et al., 2021).
Das Schadbild Glomerella Leaf Spot (GLS)
Im Frühherbst des Jahres 2020 wurde in einzelnen Apfelanlagen Südtirols das verstärkte Auftreten von nekrotischen Blattflecken (abgestorbenes Blattgewebe) beobachtet (Abb. 1). Innerhalb kürzester Zeit entwickelte sich zudem eine ausgeprägte Gelbverfärbung der Blätter (Chlorose, Abb. 2) und ein massiver, verfrühter Blattfall setzte in den betroffenen Anlagen ein. Fast zeitgleich manifestierten sich auf Früchten stecknadelkopfgroße, rötlich-braune Flecken (Abb. 3), die teilweise leicht eingesunken waren. Häufig war ein purpurfarbener Ring (auch Halo genannt) um die Infektionsstelle zu beobachten (Abb. 4). Es folgte fast vollständige Entblätterung der Bäume innerhalb eines Monats nach Auftreten der ersten Blattflecken (Abb. 5). Obwohl das Schadbild entfernt an Infektionen mit dem Alternaria-Pilz erinnerte, war eine derart rasche Symptomentwicklung in Südtirol bislang unbekannt. Umgehend wurden von der Arbeitsgruppe Phytopathologie am Versuchszentrum Laimburg umfangreiche Laboruntersuchungen durchgeführt, um der Ursache dieses Schadbildes auf den Grund zu gehen.
Mikrobiologische und molekularbiologische Identifizierung des Erregers
Im phytopathologischen Labor des Versuchszentrums Laimburg wurden Gewebeproben von nekrotischen Blatt- und Fruchtflecken entnommen und auf spezifischen Nährmedien inkubiert, um den Erreger zu isolieren. Nach wenigen Tagen war bei einem Großteil der Proben ein Pilzwachstum mit einheitlicher Morphologie erkennbar (Abb. 6). Durch die lichtmikroskopische Untersuchung der Pilzsporen wurden die Isolate der Gattung Colletotrichum sp. zugeordnet. Die Sequenzierung eines definierten Abschnittes der DNA (engl.: desoxyribonucleic acid), also der Erbinformation des Pilzes, erfolgte eine vorläufige Zuordnung des Erregers zum Colletotrichum gloeosporioides-Artkomplex (engl. Colletotrichum gloeosporioides species complex; CGSC). Durch weitere, äußerst spezifische Labortechniken und phylogenetische Analysen mit bereits beschriebenen Colletotrichum-Arten wurde auch jene Pilz-Art zweifelsfrei bestimmt, welche das GLS-Schadbild in Südtirol verursacht: Es handelt sich um Colletotrichum chrysophilum.
Das vermehrte Auftreten von Glomerella Leaf Spot (GLS) im Südtiroler Apfelanbau
Nach dem ersten Auftreten der GLS-Krankheit in Südtirol im Jahr 2020 wurde 2021 wurde kein Vorkommen der Krankheit in Südtirol registriert. Im Jahr 2022 wurde lediglich ein äußerst begrenztes, lokales Auftreten von GLS in den Apfelanlagen beobachtet, in denen die Krankheit bereits zwei Jahre zuvor nachgewiesen worden war. Hingegen waren der Spätsommer und Herbst 2023 durch ein massives Auftreten des Schadbildes und eine erhebliche Ausweitung des Befallsgebiets gekennzeichnet: GLS wurde in Anlagen der Talsohle von Terlan bis Meran beobachtet. Vereinzelte Nachweise gab es aber auch im Bozner Raum, dem Überetsch und dem Unterland. Die Befallsstärke variierte dabei erheblich von wenigen Flecken pro Frucht und Anlage bis hin zu vereinzelten Anlagen, in denen nahezu 100 Prozent der Früchte Symptome zeigten. Bei den Beobachtungen im Feld waren die Symptome bei Gala, Granny Smith und Cripps Pink(cpvr)-Rosy Glow(cpvr)-Sekzie(cpvr)/Pink Lady® sowie Golden Delicious am besten sichtbar, Fruchtflecken wurden aber auch auf CivM49(cov)/RedPop®, MC 38(cov)/Crimson Snow®, Ipador(cov)/Giga® und weiteren Sorten festgestellt. In der Literatur werden Abkömmlinge von Golden Delicious als anfällig gegenüber GLS beschrieben, wohingegen Sorten, welche von Red Delicious oder Fuji abstammen, als tolerant gelten.
Aus den Apfelanbaugebieten in Übersee, welche bereits über mehr Erfahrung mit GLS verfügen, wird berichtet, dass die GLS-Fruchtflecken während der Lagerung auf die ursprüngliche Infektionsstelle begrenzt bleiben und keine Weiterentwicklung in der Kühlzelle oder im shelf life stattfindet, sofern die Äpfel zeitnah bei niederen Temperaturen eingelagert werden. Erste Vorversuche in Südtirol bestätigen diese Erfahrungen, tiefergehende Erkenntnisse sind nach Auslagerung der Versuche der Ernte 2023 zu erwarten.
Forschungsstand zum Schadbild GLS in Europa
Obwohl GLS in einigen außereuropäischen Anbaugebieten seit längerem auftritt, gibt es aufgrund des bisher begrenzten Vorkommens in Europa keine wissenschaftlich gesicherten Informationen zu den lokalen Infektionsbedingungen und der Epidemiologie. Berichte zu GLS-Nachweisen aus anderen italienischen Apfelanbaugebieten wie der Emilia Romagna, dem Piemont und vereinzelt auch aus dem Trentino im Herbst 2023 weisen aber auf eine weitere Ausbreitung der Krankheit hin.Über die Ursachen des verstärkten Auftretens in der Vegetationsperiode 2023 können bis zur abgeschlossenen Auswertung der Daten lediglich Hypothesen aufgestellt werden, es ist jedoch anzunehmen, dass die großen Niederschlagsereignisse im Spätsommer, gefolgt von konstant hohen Temperaturen, maßgeblichen Einfluss auf das Infektionsgeschehen genommen haben.
Möglicherweise haben diese Witterungsbedingungen mit dazu beigetragen, dass im Spätsommer 2023 in Südtirol erstmals auch das Schadbild der Bitterfäule (engl.: apple bitter rot; ABR) im Feld zu beobachten war (Abb. 7). Dieses wird, genau wie GLS, durch verschiedene Colletotrichum-Arten verursacht und manifestiert sich in schwerer Fruchtfäulnis im Feld.
Obwohl GLS und ABR durch die gleichen Pilzerreger verursacht werden können, handelt es sich nach heutigem Wissensstand um zwei verschiedene Krankheiten, die aber zeitgleich auch in einer Anlage auftreten können und eine unterschiedliche Epidemiologie aufweisen.
Forschungstätigkeit zum GLS-Schadbild am Versuchszentrum Laimburg
Unmittelbar nach dem ersten Nachweis von GLS am Versuchszentrum Laimburg im Jahr 2020 begann hier eine intensive Forschungstätigkeit: Die Arbeitsgruppe Phytopathologie hat den Pilz aus den Blatt- und Fruchtflecken isoliert und in kürzester Zeit die Art Colletotrichum chrysophilum bestimmt. Es folgte zudem der wissenschaftliche Nachweis, dass diese Art die Krankheit verursacht (Deltedesco & Oettl, 2022). Die genaue Identifizierung der Art ist aufwändig, aber unerlässlich, um zielgerichtete Bekämpfungsstrategien zu entwickeln: Andere Forschungsarbeiten zeigten nämlich, dass die Wirksamkeit von Fungiziden wesentlich von der Colletotrichum-Art abhängig ist. In vitro-Screenings zur Wirksamkeit von Fungiziden, sowohl des integrierten Anbaus als auch der biologischen Produktionsweise, werden derzeit im Labor erarbeitet. Erste Bekämpfungsversuche im Freiland wurden von der Arbeitsgruppe Mittelprüfung des Versuchszentrums Laimburg in den Vegetationsperioden 2022 und 2023 durchgeführt und gaben in der vorläufigen Auswertung bereits Hinweise auf mögliche Strategien. Auch die Arbeitsgruppe Ökologischer Anbau des Versuchszentrums hat verschiedene Behandlungsversuche im Freiland durchgeführt.
Versuche zur Anfälligkeit der Früchte auf eine Infektion mit C. chrysophilum von 24 in Südtirol angebauten Apfelsorten wurden durchgeführt (Daten derzeit in Auswertung). Außerdem wurde eine Methode für die künstliche Infektion von Apfel-Sämlingen im Gewächshaus erarbeitet, sodass verschiedene Infektionsbedingungen in vivo simuliert werden können.
Mögliche Veränderungen oder Entwicklungen der GLS-Fruchtflecken während der Lagerung und des Shelf Life mit Früchten aus der Ernte 2023 werden derzeit wissenschaftlich untersucht. Eine ganze Reihe weiterer Untersuchungen der verschiedenen Arbeitsgruppen am Versuchszentrum Laimburg ist gegenwärtig in Planung und wird – auch in Kooperation mit nationalen und internationalen Versuchs- und Forschungseinrichtungen – in naher Zukunft umgesetzt werden.
Zusammenarbeit und Austausch mit anderen Forschungseinrichtungen
Die enge Zusammenarbeit des Versuchszentrums Laimburg mit dem Südtiroler Beratungsring für Obst- und Weinbau ist auch bei dieser neu auftretenden Pilzkrankheit selbstverständlich. Darüber hinaus gibt es bereits seit dem ersten Nachweis einen regen Austausch mit Wissenschaftlern und Beratern anderer Apfelanbaugebiete. Ein gemeinsames Vorgehen in Forschungs- und Versuchsfragen ist auch bei dieser Krankheit unerlässlich: Ziel ist es, die Kräfte zu bündeln und dieser weiteren Herausforderung für den Apfelanbau gemeinsam entgegenzuwirken.
Bilder

Symptome: Als erste Symptome von GLS zeigen sich purpurfarbene-braune nekrotische Blattflecken.

Verfärbung der Blätter: Im fortgeschrittenen Stadium kann sich verstärkt eine chlorotische Verfärbung der Blätter manifestieren.

Fruchtflecken: Die typischen GLS-Fruchtflecken weisen einen Durchmesser von ca. ein bis drei Millimeter auf, sind rötlich-braun und können leicht eingesunken sein, hier bei der Sorte Golden Delicious.

Infektionsstelle: Vor der Ausprägung der roten Deckfarbe zeigt sich um die Infektionsstelle häufig ein purpurfarbener Ring (Halo), hier bei der Sorte Rosy Glow(cpvr).

Entblätterung: Eine frühzeitige, nahezu vollständige Entblätterung der Apfelbäume innerhalb weniger Wochen nach dem Auftreten der ersten Blattflecken ist typisch für GLS.
Colletotrichum chrysophilum: Ein Isolat von Colletotrichum chrysophilum auf Nährmedium

Bitterfäule: Im Herbst 2023 war in den Südtiroler Apfelanlagen erstmals auch das Schadbild der Bitterfäule (ABR), ebenfalls hervorgerufen durch Colletotrichum-Pilzarten, zu beobachten.